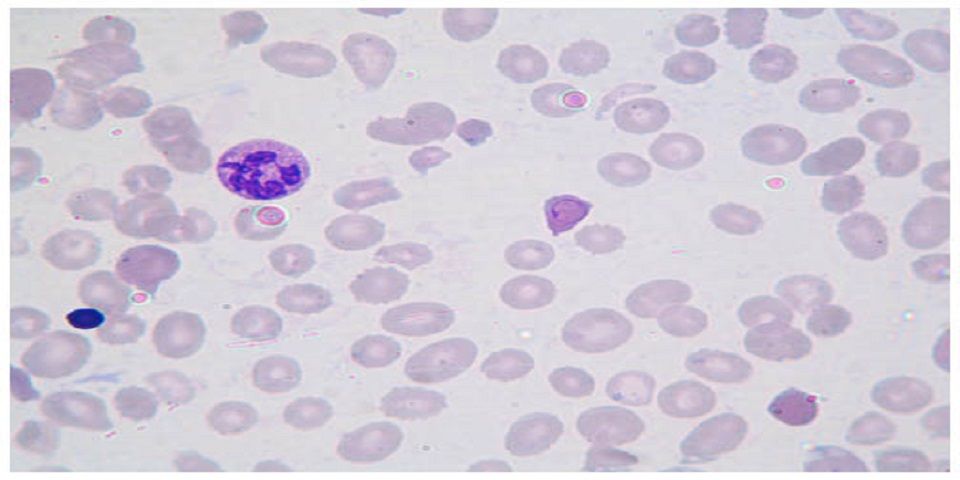

Desarrollan en Cinvestav un dispositivo en biochip que ayudará a pacientes y a médicos con lupus a un mayor control de la enfermedad
En el Centro de Investigación y de Estudios Avanzados (Cinvestav) unidad Monterrey, se está desarrollando un dispositivo médico que ayudará a pacientes con padecimiento de lupus a tener un mejor control y tratamiento sobre esta enfermedad autoinmune.
Rocío Jiménez Valdés, investigadora del Cinvestav, bajo la supervisión del doctor José Luis García Cordero, es quien se encarga de la realización de los estudios de los neutrófilos para poder monitorear la enfermedad lupus eritematoso sistémico (LES) a través del biochip con técnicas de manipulación de fluidos en escala de micras.
La científica explicó que decidió crear este dispositivo para beneficio de los pacientes con lupus, que es la principal enfermedad autoinmune a nivel mundial, de la cual, según datos de la Organización Mundial de la Salud (OMS), cinco por ciento de la población la padece.

El lupus es una enfermedad crónica en la que el sistema inmunitario del cuerpo ataca por error el tejido sano. Este padecimiento puede atacar la piel, articulaciones, riñones, cerebro y otros órganos, además de que es mucho más común en mujeres que en hombres y puede presentarse a cualquier edad. No obstante, aparece con mayor frecuencia en personas cuyas edades están comprendidas entre los 10 y 50 años.
“Con el desarrollo del biochip voy a caracterizar las poblaciones de neutrófilos, esto se refiere a las células del sistema inmunológico que responden ante inflamaciones, y con base en su respuesta ante un estímulo determinado se van a ir asociando las poblaciones a diferentes grados de lupus”, explicó Jiménez Valdés.
El dispositivo será usado por médicos y la idea es que sea una detección rápida, en tan solo 10 minutos, y saber en qué etapa se encuentra el desarrollo del lupus.
“El médico podrá incrementar la dosis de tratamiento o disminuirla, además de prevenir recaídas, es decir si en la prueba se detectan los neutrófilos estables, se podría bajar la dosis del medicamento, por lo que se recomienda al paciente realizarse esta prueba por lo menos una vez al mes”, explicó la investigadora Jiménez Valdés.
Redacción